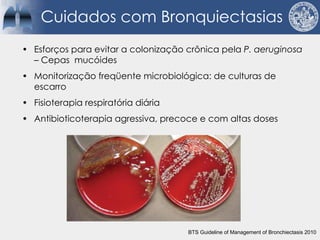
Cuidados com Bronquiectasias
• Esforços para evitar a colonização crônica pela P. aeruginosa
– Cepas mucóides
• Monitorização freqüente microbiológica: de culturas de
escarro
• Fisioterapia respiratória diária
• Antibioticoterapia agressiva, precoce e com altas doses
BTS Guideline of Management of Bronchiectasis 2010

Bronquiectasias são causadas por inflamação crônica que destrói as vias aéreas e leva à distorção delas. Isso causa anormalidades no clearance mucociliar e colonização bacteriana. O tratamento envolve fisioterapia respiratória, solução salina hipertônica, antibióticos inalatórios e macrolídeos para reduzir inflamação e infecções, melhorando os sintomas e a qualidade de vida dos pacientes.





















![Dornase-alfa
– Fibrose cística
‣ Melhora função pulmonar
‣ Diminui frequência de exacerbações
– Bronquiectasia não fibrose cística
‣ Exacerbações mais frequentes
‣ Maiores taxas de hospitalização
‣ Maior uso de antibióticos e corticóides
1-O'Donnell AE, Barker AF, Ilowite JS, Fick RB. Treatment of idiopathic bronchiectasis with aerosolized recombinant human DNase I.
rhDNase Study Group. Chest. [Clinical Trial Multicenter Study Randomized Controlled Trial Research Support, Non-U.S. Gov't]. 1998
May;113(5):1329-34.
2-Rogers DF. Mucoactive agents for airway mucus hypersecretory diseases. Respiratory care. [Review]. 2007 Sep;52(9):1176-
93; discussion 93-7.](https://image.slidesharecdn.com/6-221009024403-299876a4/85/6-Bronquiectasias-pdf-22-320.jpg)